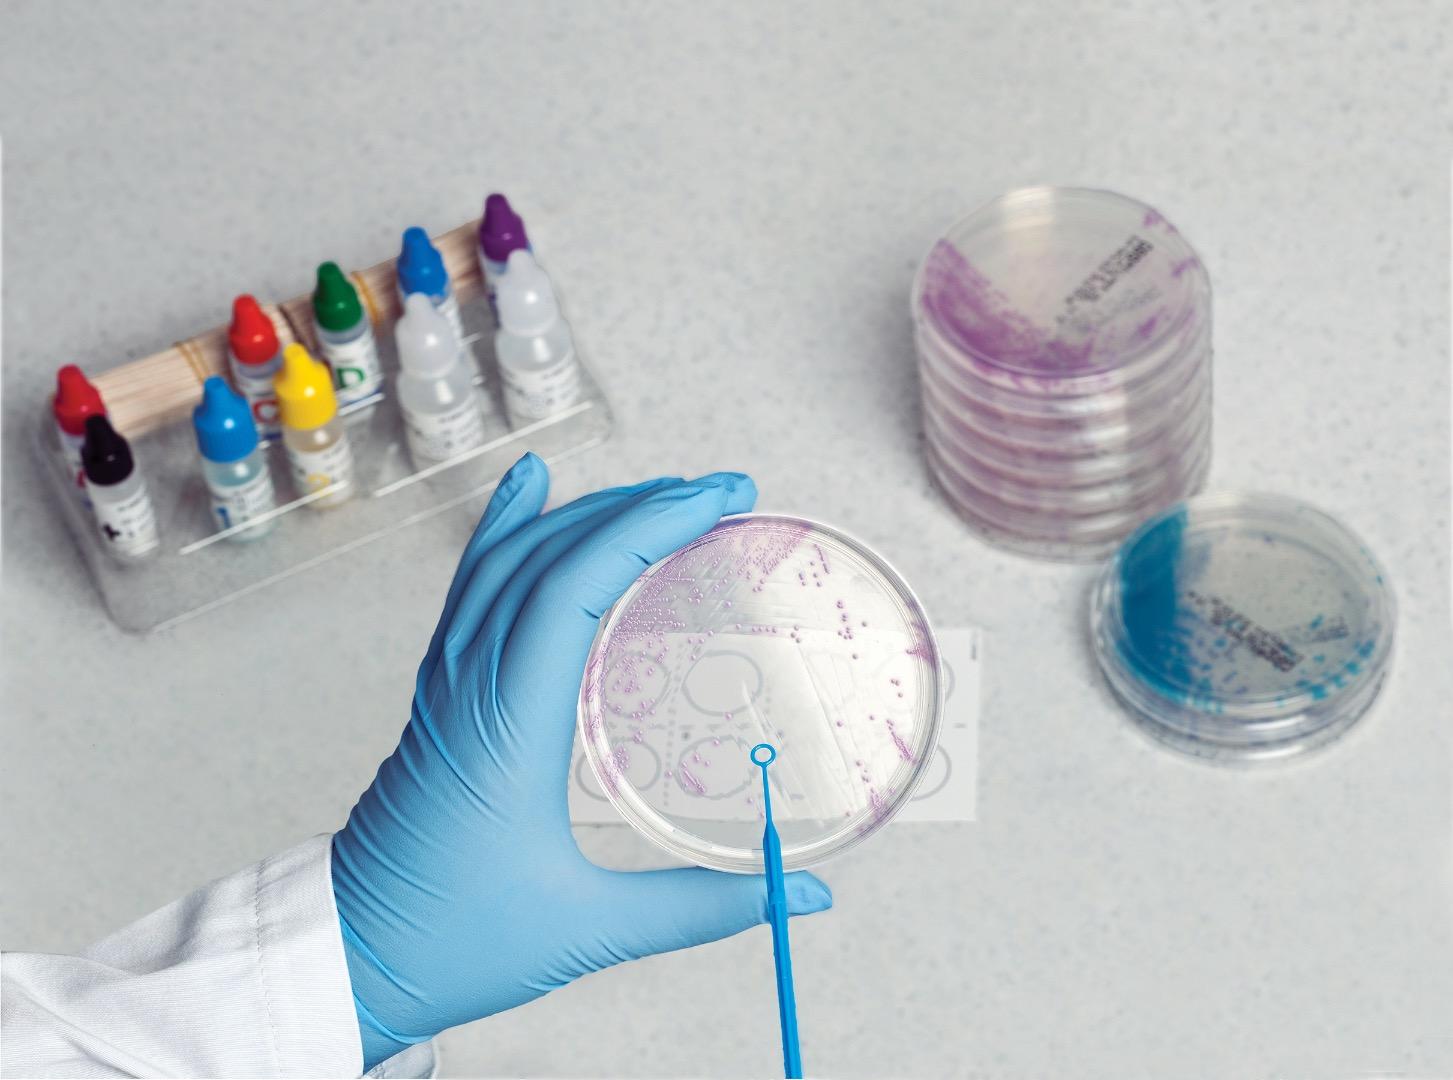
远离母婴杀手!谈美国产检之b型链球菌gbs筛查

b族链球菌检测

b族链球菌快速检测卡
图片尺寸1024x1448
b族链球菌顺利通过啦 b族链球菌结果今天出了,阴性顺利通过.
图片尺寸2276x1280
圣湘生物b族链球菌核酸检测试剂盒pcr荧光探针法取得医疗器械注册证
图片尺寸700x1244
b族链球菌核酸检测试剂盒荧光pcr法
图片尺寸450x300
b族链球菌
图片尺寸500x375
学名无乳链球菌,是一种常见的阴道和肠道定殖菌,所
图片尺寸961x1280
b族链球菌gbs核酸检测试剂盒pcr荧光探针法
图片尺寸640x428
圣湘生物自主研发的b族链球菌gbs核酸检测试剂盒荧光探针法通过国家
图片尺寸1080x864
gbs学名无乳链球菌,正常寄居于阴道和直肠,它是一种条件致病菌,一般
图片尺寸1280x1280
373 有孕妈检查b族溶血性链球菌感染的吗?
图片尺寸750x640
孕期记录|37周b族链球菌弱阳转阴了 b族链球菌算是整个产检的最后一道
图片尺寸960x1280
camp实验(初步鉴定b群链球菌的实验)_摘编百科
图片尺寸586x679
b族链球菌顺利通过啦 b族链球菌结果今天出了,阴性顺利通过.
图片尺寸960x1280
港口医院检验科开展"无乳链球菌(b群链球菌)检测"
图片尺寸2000x2667
孕晚期很重要的一项产检项目b族链球菌检测你做了吗
图片尺寸828x349
不容忽视的孕期检测项目b族链球菌
图片尺寸548x385
世界早产日:b族链球菌感染与胎膜早破 丨 广东阳光生物_孕妇_筛查
图片尺寸800x443
这b族链球菌的结果是阴性还是阳性?求专家
图片尺寸640x360
b族链球菌呈阳性
图片尺寸750x1334
远离母婴杀手!谈美国产检之b型链球菌gbs筛查
图片尺寸1453x1080